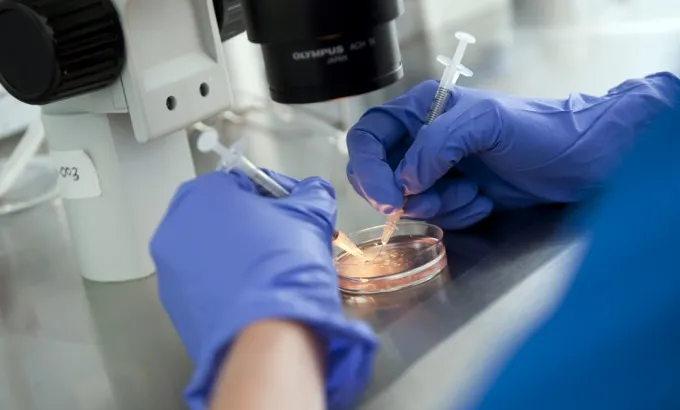

What should the relationship be between Church and State?
Question: I have no doubt that the Church has the right to give its opinion on civil matters; it is our spiritual guide for that


Question: I have no doubt that the Church has the right to give its opinion on civil matters; it is our spiritual guide for that

Question: Dear brother: Could you inform me about hypnotism? To what extent is it permitted or accepted? Please give me your pertinent comments. Blessings.

Question: Father: Did Adam really exist or is he an allegory? How should we interpret the texts of Genesis? Answer: ETYMOLOGY AND USE OF THE

Question: Dear Father, We are a Catholic couple with three beautiful children, and we wish to have more. However, when we mention this to other

Question: We are sending this email to inquire if you know the etymology, or the exact origin of the formation of the word ‘Mass’. We

Question: Does the Catholic Church accept the marriage of a Catholic person with a Christian belonging to a different church, considering that neither of them

Question: I am addressing you in the most respectful manner to ask your opinion on a delicate topic. The question would be: In what way

Question: The purpose of this email is to kindly request that you send me material on the proofs a Catholic can provide regarding the divine

Question: I have received several objections on this topic that challenge this truth; for example: “Read the New Testament, where does it mention Mary’s role?

Question: Why should I confess to a priest? Thank you. Answer: Dear [Recipient], Because that is how Jesus Christ instituted it. ‘Whose sins you

Question: Good afternoon Father, I hope you can answer me; you know, I want to ask you if after having made the sacrament of confession

Question: An acquaintance asked me about the original sin and I referred to the story as it is found in the book of Genesis in

Question: What is the problem with transplants, and what is the issue regarding “criteria for death” for the case of some transplants? Answer: The subject

Question: God bless your work; the teaching you will give us will do a lot. We work on teaching the Billings method and are continually
Do you have a question? Send it to us, and we will try to answer in short…
You can fill out this form